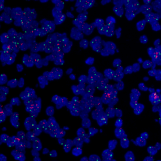

病理服务平台
-服务简介-
组织病理学是全球肿瘤诊断的金标准,免疫组织化学(IHC)是分析组织样本的核心平台。在肿瘤药物研发过程中,对基于IHC平台的定量组织生物标志物的需求越来越大,要求生物标志物分析和药物开发平行进行, 生物标志物分析要求随药物开发的每个阶段而变化。目前平台具有400个病理诊断级别抗体,全部通过组织芯片(TMA)验证,多个全自动免疫组化仪平台可供选择,多重免疫荧光检测及全景扫描平台,能够对图像进行定量分析处理
应用领域
- 药物发现阶段:生物标志物IHC检测
- 靶点确证/药效学:早期靶点/药物疾病定位和理论基础验证
- 先导化合物优化/临床前:PK/PD分析;预测建模、生物标志物策略开发和进一步的疾病定位
- 临床I/II期:I期/II PoM生物标志物部署和患者选择策略构建
相关设备和软件
- Leica BondMAX
- Roche Ventana Benchmark Ultra
- FAIP-48T
应用示例

示例1:全切片扫描定量分析
多重荧光染色结合精准的软件定量分析实现组织水平的类似流式细胞仪的定量统计结果,分析不同细胞在样品中的百分比,只需少量样本,便能最大限度的获得多个信息, 同一切片可实现3个生物标志物染色,检测灵敏度较普通IHC提高近100倍,无需考虑一抗的种属,更好的分析多重靶标的共表达及空间定位。 组织切片原位染色又弥补了流式细胞计数的形态缺失,结合距离、浸润深度等空间分析技术,构建起一个蛋白功能研究和微环境研究的网络。
示例2:生物标志物IHC检测
在药物研发管线的所有阶段均使用IHC分析,并结合越来越多的其他对照平台,寻找能够在临床前模型中提供靶标/信号通路和PoM/PoP的准确重现分析, 其结果可用于临床试验设计。成功的IHC分析最重要的两个要素是可靠的抗体和组织样本完整性。目前平台具有400个病理诊断级别抗体, 全部通过组织芯片(TMA)验证,并且提供多个全自动免疫组化仪平台可供选择,提供可靠,稳健的实验条件。


示例3:伴随诊断开发的可行性研究
药物伴随诊断能够显著提升靶向药的客观应答率,过去 15 年内批准的靶向药物中, 有伴随诊断的药物客观应答率 "ORR" 为 41%-80%,而无伴随诊断药物客观应答率为 7%-45%, 同时对于诊疗过程的所有参与方如患者、药企、医院等都有重要价值